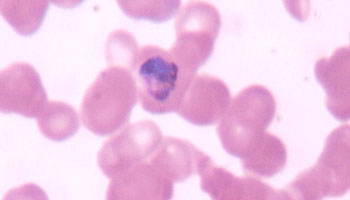

DTN News: China - Breaking Headlines News Dated January 20, 2011
Source: DTN News - - This article compiled by Roger Smith from reliable sources XinhuaNet.com(NSI News Source Info) TORONTO, Canada - January 20, 2011: Comprehensive daily news related to China Breaking - Headlines Newsfor the world of TODAY.

*Comprehensive daily news related to China - Breaking Headlines News for the world of TODAY


In Pictures: Chinese President Hu Jintao's visit to U.S.
China and U.S. have agreed to further boost their bilateral relationship toward a cooperative partnership.
|
*This article is being posted from Toronto, Canada By DTN News ~ Defense-Technology News, contact: dtnnews@ymail.com

DTN NEWS ON TWITTER (30 SUBJECTS)

No comments:
Post a Comment